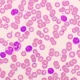
Leucemia linfocítica crónica

El abdomen agudo es un término médico que se utiliza para describir una condición médica grave y potencialmente mortal que afecta al abdomen. Se refiere a la aparición repentina y severa de síntomas abdominales que pueden indicar una enfermedad o afección grave que requiere atención médica inmediata.
Causas
El abdomen agudo puede ser causado por una variedad de condiciones médicas graves entre las que se incluyen:
- Apendicitis aguda: Es la inflamación del apéndice, una pequeña estructura en forma de tubo que se encuentra en el inicio del intestino grueso. La apendicitis aguda suele presentarse con dolor abdominal en el lado derecho, fiebre, náuseas y vómitos. Si no se trata adecuadamente, el apéndice puede perforarse, lo que conlleva a complicaciones graves y potencialmente mortales.
- Perforación de órganos abdominales: La perforación de órganos como el estómago, el intestino delgado o el colon puede ocurrir debido a condiciones como úlceras pépticas, enfermedad inflamatoria intestinal o diverticulitis. Una perforación causa dolor abdominal intenso, rigidez y signos de infección en la cavidad abdominal, lo cual puede conducir a una peritonitis, una inflamación severa del revestimiento abdominal.
- Obstrucción intestinal: La obstrucción del intestino puede ser causada por varias condiciones, como una hernia estrangulada, bridas o adherencias postoperatorias, tumores intestinales o enfermedades inflamatorias intestinales como la enfermedad de Crohn. Los síntomas incluyen dolor abdominal, distensión, vómitos, estreñimiento y la incapacidad de pasar gases o heces.
- Diverticulitis: Los divertículos son pequeñas bolsas que se forman en la pared del colon. La diverticulitis ocurre cuando estas bolsas se inflaman o se infectan, causando dolor abdominal intenso en el lado izquierdo, fiebre, náuseas y cambios en los hábitos intestinales. En casos graves, puede haber complicaciones como abscesos o perforación del colon.
- Pancreatitis aguda: La inflamación del páncreas puede ser causada por cálculos biliares, consumo excesivo de alcohol, infecciones o ciertos medicamentos. Los síntomas incluyen dolor abdominal intenso que se irradia hacia la espalda, náuseas, vómitos, fiebre y distensión abdominal.
- Colecistitis aguda: Es la inflamación de la vesícula biliar, generalmente debido a la presencia de cálculos biliares que bloquean los conductos. Los síntomas típicos son dolor abdominal intenso en el lado derecho, fiebre, náuseas y vómitos. Si no se trata, la vesícula biliar puede infectarse o perforarse, lo que representa un riesgo grave.
- Isquemia intestinal: Ocurre cuando hay una disminución o interrupción del flujo sanguíneo al intestino, lo cual puede ser causado por una obstrucción arterial, trombosis venosa o embolia. La isquemia intestinal provoca dolor abdominal severo, sensibilidad al tacto, distensión, diarrea o sangre en las heces, y puede conducir a la muerte del tejido intestinal si no se trata rápidamente.
- Torsión o estrangulación de hernia: Una hernia se produce cuando un órgano o tejido sobresale a través de una abertura o debilidad en la pared muscular. En algunos casos, la hernia puede torcerse o estrangularse, lo que interrumpe el flujo sanguíneo al órgano herniado. Esto causa un dolor abdominal intenso, acompañado de náuseas, vómitos y distensión abdominal.
- Oclusión arterial mesentérica: La oclusión arterial mesentérica es una obstrucción en una o más arterias que suministran sangre al intestino. Esto puede deberse a la formación de coágulos sanguíneos, embolias o aterosclerosis. La falta de flujo sanguíneo adecuado puede provocar dolor abdominal severo y repentino, a menudo asociado con diarrea sangrienta, deshidratación y shock.
- Perforación de úlcera gástrica: Una úlcera gástrica es una lesión en el revestimiento del estómago. Si una úlcera perfora completamente la pared del estómago, los ácidos y los contenidos gástricos pueden filtrarse hacia la cavidad abdominal, lo que provoca una peritonitis. Esto se manifiesta con dolor abdominal agudo, rigidez abdominal, fiebre y signos de infección.
- Tumores abdominales: Los tumores abdominales, ya sean benignos o malignos, pueden provocar un abdomen agudo si interfieren con la función normal de los órganos o si se produce una complicación, como la perforación del tumor. Dependiendo de la ubicación y el tipo de tumor, los síntomas pueden variar y pueden incluir dolor abdominal, distensión, pérdida de peso y cambios en los hábitos intestinales.
- Embarazo ectópico roto: Un embarazo ectópico ocurre cuando un óvulo fertilizado se implanta fuera del útero, generalmente en una de las trompas de Falopio. Si el embarazo ectópico se rompe o se produce una hemorragia interna, puede presentarse un abdomen agudo con dolor abdominal intenso y agudo, sangrado vaginal anormal y signos de shock.
- Infecciones intraabdominales: Las infecciones intraabdominales pueden ser causadas por bacterias que invaden los órganos abdominales o el líquido que los rodea. Las causas pueden incluir apendicitis perforada, diverticulitis perforada, absceso intraabdominal o peritonitis bacteriana espontánea. Los síntomas suelen incluir dolor abdominal intenso, fiebre, náuseas, vómitos y signos de infección.
- Enfermedades inflamatorias del intestino: Enfermedades como la colitis ulcerosa y la enfermedad de Crohn pueden provocar episodios de abdomen agudo en casos raros. Esto puede ocurrir debido a la obstrucción del intestino, perforación de las paredes intestinales, formación de abscesos o complicaciones relacionadas con el tratamiento médico.
- Pancreatitis hereditaria: Algunas formas raras de pancreatitis tienen un componente genético, y las personas afectadas pueden experimentar episodios recurrentes de abdomen agudo debido a la inflamación crónica del páncreas. Estos episodios se caracterizan por dolor abdominal intenso, náuseas, vómitos y distensión abdominal.
- Enfermedades vasculares: En raras ocasiones, ciertas enfermedades vasculares pueden provocar un abdomen agudo. Por ejemplo, la arteritis de Takayasu, una enfermedad inflamatoria de los vasos sanguíneos grandes, puede afectar las arterias que irrigan el intestino y causar isquemia intestinal. También, la trombosis de la vena esplénica puede llevar a una congestión venosa y a un abdomen agudo.
- Síndrome compartimental abdominal: Este síndrome ocurre cuando la presión dentro de la cavidad abdominal aumenta significativamente, generalmente debido a un traumatismo, una cirugía o una hemorragia interna. El aumento de la presión puede comprimir los órganos y los vasos sanguíneos, lo que lleva a un flujo sanguíneo insuficiente y daño tisular. Se presenta con dolor abdominal intenso, distensión, disminución del gasto urinario y signos de disfunción de múltiples órganos.
- Infecciones parasitarias: Aunque poco comunes, algunas infecciones parasitarias pueden causar abdomen agudo. Por ejemplo, la infección por anquilostomas puede provocar una condición llamada enteritis verminosa, en la cual los parásitos se adhieren a la pared intestinal, causando daño y provocando dolor abdominal agudo y diarrea.
- Vasculitis abdominal: Algunas formas raras de vasculitis, como la poliarteritis nodosa y la enfermedad de Kawasaki, pueden afectar los vasos sanguíneos del abdomen y causar inflamación, obstrucción y daño tisular. Esto puede dar lugar a un abdomen agudo con dolor abdominal intenso, fiebre y síntomas relacionados con la disfunción de órganos.
Manifestaciones clínicas
El abdomen agudo se caracteriza por la aparición repentina de síntomas y signos que indican una enfermedad o afección grave que afecta al abdomen. Estas manifestaciones pueden variar dependiendo de la causa subyacente:
- Dolor abdominal: El dolor es uno de los síntomas principales del abdomen agudo. Puede ser intenso, constante y localizado en una zona específica o difuso en todo el abdomen. La ubicación y la intensidad del dolor pueden variar según la causa subyacente.
- Sensibilidad al tacto: El abdomen puede volverse sensible al tacto, lo que significa que cualquier presión o manipulación del área abdominal puede provocar dolor intenso.
- Distensión abdominal: La distensión o hinchazón del abdomen es común en el abdomen agudo. El abdomen puede sentirse abultado, tenso y aumentado de tamaño.
- Náuseas y vómitos: Muchas veces, el abdomen agudo se acompaña de náuseas y vómitos. Esto puede ser el resultado de la irritación o inflamación de los órganos abdominales, así como de la respuesta del cuerpo al dolor intenso.
- Cambios en los hábitos intestinales: Dependiendo de la causa subyacente, el abdomen agudo puede manifestarse con cambios en los hábitos intestinales. Esto puede incluir estreñimiento, diarrea o incluso la incapacidad para eliminar gases o heces.
- Fiebre: En algunos casos, el abdomen agudo puede ir acompañado de fiebre, que es una respuesta del cuerpo a la inflamación o infección presente en el abdomen.
- Rigidez abdominal: El abdomen agudo puede causar rigidez o tensión en los músculos abdominales. Cuando se palpa el abdomen, puede sentirse rígido e incluso puede haber resistencia a la palpación.
- Taquicardia: El corazón puede aumentar su ritmo cardíaco en respuesta al dolor y al estrés causados por el abdomen agudo. La taquicardia (aumento de la frecuencia cardíaca) es un signo que puede estar presente durante un episodio de abdomen agudo.
- Palidez cutánea: En casos más graves, el abdomen agudo puede afectar el flujo sanguíneo adecuado a través del cuerpo, lo que puede provocar palidez cutánea. La piel puede volverse pálida y fría debido a la disminución del flujo sanguíneo periférico.
- Hipotensión: En situaciones de abdomen agudo grave, la presión arterial puede disminuir, lo que se conoce como hipotensión. Esto puede deberse a la pérdida de líquidos, a una respuesta inflamatoria sistémica o a la disminución del flujo sanguíneo a los órganos.
- Signos de shock: En casos severos y no tratados, el abdomen agudo puede llevar a un estado de shock, donde hay una disminución crítica del flujo sanguíneo a los órganos vitales. Los signos de shock incluyen pulso débil, respiración rápida y superficial, confusión, mareos y disminución de la producción de orina.
Es importante tener en cuenta que las manifestaciones del abdomen agudo pueden variar según la causa subyacente y la gravedad de la afección.

Síguenos en X: @el_homomedicus y @enarm_intensivo Síguenos en instagram: homomedicus y en Treads.net como: Homomedicus